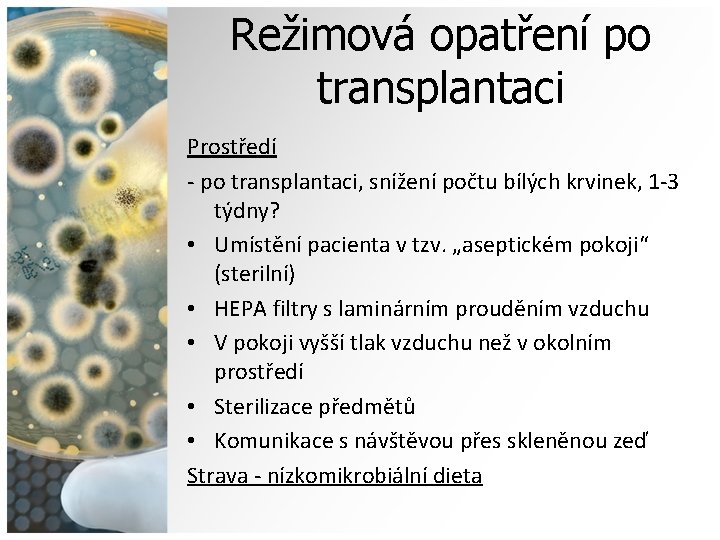
Režimová opatření po transplantaci Prostředí - po transplantaci, snížení počtu bílých krvinek, 1 -3

Nzkomikrobiln strava Mgr Kateina Krkov Mgr Jana Stvkov

Nízkomikrobiální strava Mgr. Kateřina Krčková Mgr. Jana Stávková

Teoretická část • Protinádorová chemoterapie a nežádoucí účinky • Transplantace krvetvorných buněk a režimová opatření po transplantaci • Neutropenie • Mikroorganismy v potravinách • Nízkomikrobiální strava

CHT a nežádoucí účinky • Léčba zhoubných nádorů; přípravná fáze na transplantaci kostní dřeně • NÚ: nevolnost a zvracení, mukozitida, průjem, zácpa, nechutenství, bolest, kardiotoxicita, nefrotoxicita, neurotoxicita, plicní toxicita, kožní toxicita, hepatotoxicita, gonadotoxicita • Útlum kostní dřeně, tj. krvetvorby (myelosuprese) - krvácivé projevy, anémie • Snížená obranyschopnost organismu → infekční komplikace !!! NEUTROPENIE

Neutropenie = Snížení počtu bílých krvinek (neutrofilních granulocytů) pod 1, 0. 109/l snížená obranyschopnost Neutrofilní granulocyty • Nejpočetnější složka bílých krvinek • Schopnost fagocytózy (pohlcení a destrukce cizorodých látek v těle) • Chrání organismus před mikroorganismy pronikajícími do těla (bakterie, viry, plísně) Výrazný pokles těchto buněk imunitního systému snižuje schopnost organismu bránit se proti infekcím a zvyšuje riziko vzniku komplikací nejen u onkologicky nemocných pacientů • Zdrojem infekce: vnější prostředí, potraviny

Neutropenie • Vznik v důsledku chemoterapeutické léčby • Jako následek transplantace krvetvorných buněk a užívání imunosupresivních léčiv 3 stupně neutropenie: • Mírná - počet neutrofilů < 1, 0. 109/l - mírné riziko infekce • Středně závažná < 0, 5. 109/l – střední riziko infekce • Velmi závažná < 0, 1. 109/l – velmi vysoké riziko infekce

Transplantace kostní dřeně • Léčba poruch krvetvorby, imunodeficience, některých druhů zhoubných nádorových onemocnění (např. leukemie, lymfom, mnohočetný myelom) • Podání krvetvorných buněk do žíly Rozdělení: • a) autologní (transplantace vlastní kostní dřeně téhož pacienta) • b) alogenní (dárcem „cizí“ dárce) • c) syngenní (dárcem jednovaječné geneticky identické dvojče)

Přípravný režim k transplantaci • Podstoupení několikadenní vysokodávkové CHT (či RT)- riziko: NÚ stejné jako u protinádorové CHT, ale větší intenzita NÚ (vyšší dávky) • Cíl: zničit maligní klon nádorových buněk, potlačit imunitní systém pacienta a uvolnit místo pro „nové“ buňky • Součástí přípravného režimu (i potransplantačního) je podávání imunosupresivních léků +/ snižují odmítnutí štěpu, -/ výrazně oslabují imunitu pacienta (snižují počet bílých krvinek)

Autologní transplantace Imunosupresiva nejsou nutná Alogenní transplantace Nutná imunosupresiva Reakce štěpu proti hostiteli

Režimová opatření po transplantaci Edukace • Nemocný, rodina, příbuzní, personál • Hraje významnou úlohu v prevenci vzniku infekce Podpůrná léčba • ATB, protiplísňové léky, imunoglobuliny, růstové faktory, infuze-krevní destičky, červené krvinky Hygiena • Každodenní celotělová hygiena, koupel po stolici • Časté mytí rukou (po toaletě, před jídlem) + dezinfekce • Hygiena o DÚ měkkým kartáčkem • Ochrana pokožky před zraněním, poškozením • Péče o žilní kanyly • Vyhýbat se vyšetření per rectum, podávání rektálních čípků, zavádění močových katetrů
Režimová opatření po transplantaci Prostředí - po transplantaci, snížení počtu bílých krvinek, 1 -3 týdny? • Umístění pacienta v tzv. „aseptickém pokoji“ (sterilní) • HEPA filtry s laminárním prouděním vzduchu • V pokoji vyšší tlak vzduchu než v okolním prostředí • Sterilizace předmětů • Komunikace s návštěvou přes skleněnou zeď Strava - nízkomikrobiální dieta

Režimová opatření po transplantaci

Režimová opatření po transplantaci Prostředí - po zvýšení počtu bílých krvinek • Přemístění pacienta na pokoj s označením „izolační pokoj“ • Co nejmenší počet osob na jednom pokoji, bez infekce • Vstup do pokoje s rouškou na ústech, dezinfekce rukou • Na pokoji nejsou živé květiny, zvlhčovače vzduchu • Denní úklid, neprášit • V domácím prostředí se vyhýbat místům s

Režimová opatření po transplantaci

Nízkomikrobiální dieta = neutropenická (neutropenic diet), sterilní, nízkobakteriální • Cíl: snížit riziko vzniku alimentárního onemocnění • ? Indikace: dle počtu neutrofilů (< 0, 5 x 109 /l), týden/den před transplantací, na začátku přípravného režimu- nejednotné názory • Doporučená délka dodržování diety: o Po alogenní transplantaci 6 měsíců o Po autologní transplantaci 1 -3 měsíce o Dle počtu neutrofilů (>1 x 109 /l) • V nemocnici brána jako dieta izolační • Pacient dbá na osobní hygienu, vyhýbá se rizikovému prostředí (velké množství lidí), používá roušku na ústa, omezený kontakt se zvířaty, vyskytuje se v čistém prostředí (uklizené místnosti)

Zásady nízkomikrobiální diety

Zásady nízkomikrobiální diety • Potraviny zdravotně nezávadné, bez podezřelé barvy, vůně, konzistence • Kontrolujeme neporušenost obalu, doba použitelnosti/ trvanlivosti • Vhodné skladovací podmínky • Tepelné zpracování potravin! • Připravenou stravu podávat pouze čerstvou • Hygiena při manipulaci s potravinami, přípravě pokrmů • Čisté nádobí, náčiní a utěrky • Nestravovat se ve veřejných stravovacích zařízeních (restaurace, rychlé občerstvení, točená zmrzlina) • Voda jen z ověřeného zdroje, převařená nebo speciální minerální vody • Koření nepřidávat do hotového pokrmu

Mléko a mléčné výrobky Vhodné • Mléko - jen označené UHT, sterilizované vysokou teplotou (ne dlouho otevřené) • Tavené sýry, tvrdé sýry - zabalené v alobalu, vakuově balené • Mléčné výrobky vyrobené z mléka ošetřeného UHT - krémové sýry, cottage, ricotta • Jogurty (bez živých kultur, např. termizované tvarohy, termix, Lipánek, Créme pudink, Danette, Monte) Nevhodné • • • Čerstvé sýry, krájené vážené sýry - prodávané v supermarketech za pultem s masnými výrobky Plísňové sýry (niva, hermelín, roquefort, gorgonzola), kysaná smetana, zrající sýry (tvarůžky, Romadur) Jogurty obohacené živými kulturami Zakysané mléčné výrobky Sýry obsahující tepelně neupravenou zeleninu (jen přírodní sýry)

Probiotika „FAO/WHO charakterizuje probiotikum jako živé mikroorganismy, které v adekvátním množství působí pozitivně na zdraví člověka. “ • • • Příznivě působí na střevní mikroflóru Chrání střevní sliznici před vznikem infekcí Zmírňují příznaky laktátové intolerance Zlepšují funkci imunitního systému Snižují hladinu sérového cholesterolu Prevence průjmových onemocnění…. Označení „probiotický“ počet živých mikroorganismů ve finálním výrobku musí být alespoň 106 – 108 KTJ/ml

Probiotika POZOR! • i přes pozitivní účinky probiotik na lidský organismus existují případy, kdy se užívání probiotik nedoporučuje! – onemocnění narušující funkci imunitního systému (HIV/AIDS), autoimunitní onemocnění (lupus erythematodes, Sjögrenův syndrom, revmatoidní arthritis), některá nádorová onemocnění (leukemie) léčená CHT či imunosupresivy • Protinádorová léčba narušuje střevní sliznici (zabraňuje průniku MO do krevního řečiště), v kombinaci s probiotiky může zvýšit riziko infekce, proto se probiotikům raději vyhýbáme nebo jejich užívání konzultujeme s lékařem • Výrobky s největším množstvím probio kultur - firma Danone, Meggle, Hollandia, Olma, Mlékárny Valašské Meziříčí (jogurty z Valašska), Laktos (Pacholík, Smetánek)

Maso a uzeniny Vhodné • Jakékoliv druhy masa a uzenin - dobře tepelně upraveny nebo konzervovány • Salámy a šunky - komerčně zabalené, vakuově balené • Párky - uvařené (omezeně) Nevhodné • Zabíjačky (tlačenky, ovary, sekaná apod. ) • Syrové maso (např. „tatarák“) • Domácí uzené maso a klobásky • Salámy s plísní na povrchu (maďarské salámy) • Uzeniny vyráběné sušením syrového masa (Lovecký, Poličan, Herkules, Čabajka) • Krájené vážené salámy prodávané za pultem

Pečivo, přílohy, pochutiny Vhodné • Všechny čerstvé druhy pečiva • Bramborové chipsy, preclíky, popcorn, tortilla, palačinky, vafle • Vařené obiloviny a obilné výrobky, těstoviny, rýže, brambory Nevhodné • Špatně skladované pečivo (např. v igelitových sáčcích – riziko zaplísnění!) • Tepelně neupravené obilné výrobky • Pečivo a cereálie obsahující tepelně neupravené ořechy (pečivo s obsahem semen – slunečnice, sezam, len, mák) • Bramborový salát se syrovou zeleninou nebo vejci

Ryby, dary moře Vhodné • Všechny zmrazené, konzervované nebo čerstvé, ale dobře tepelně upravené (přes 70 °C). Nevhodné • Syrové (sushi), uzené (makrely), marinované (pečenáče, zavináče) • Tepelně nezpracované mořské plody (např. ústřice) Vejce Vhodné • Dobře tepelně upravené (omeleta, vařené natvrdo, míchaná – dostatečně dlouho) Nevhodné • Syrová, „ztracená“ vejce, vařená naměkko

Ovoce, ořechy Vhodné • Ovoce, které lze oloupat nebo dobře umýt • Kompoty a džemy - komerčně vyrobené • Ořechy - tepelně upravené v pečivu Nevhodné • Jahody, maliny, ostružiny, rybíz, třešně, švestky a další ovoce, které nejde dobře umýt • Ořechy a sušené ovoce (bývají častým zdrojem plísní)!

Zelenina Vhodné • Všechna tepelně upravená, sterilovaná • Z čerstvých druhů pouze ty, které lze oloupat, případně dobře umýt Nevhodné • Cibule a česnek - čerstvé • Syrový salát, čínské zelí a restovaná zelenina • Kysané zelí a zelenina konzervovaná kvašením

Tuky Vhodné • Máslo, margaríny, kvalitní rostlinné oleje, chlazené vepřové sádlo • Komerčně vyrobené majonézy a salátové dresinky Nevhodné • Domácí majonézy a salátové dresinky (čerstvá vejce) Dezerty Vhodné • Domácí nebo kupované sladké koláče, pečivo, pudinky • Žvýkačky, želé bonbony, tvrdé bonbony, sušenky, piškoty • Jednotlivé balení zmrzliny (nanuk) Nevhodné • Krémové pečivo, zákusky, čokoláda, točená zmrzlina • Dezerty s tepelně neupravenými ořechy • Tepelně neupravené vločky a müsli • Zmrzlina v kornoutku

Ostatní Vhodné • Sůl, cukr, ocet • Koření (tepelně zpracované) • Komerčně pasterizovaný med • Sirup, kečup, hořčice, sójová omáčka, maggi, olivy - po otevření skladovat v lednici • Konzervovaná dětská výživa Nevhodné • Syrový med • Pivovarské kvasnice (pokud nejsou tepelně upraveny) • Kakaový prášek • Mák, sezam • Sušené houby • Instantní pokrmy • Koření, které nebylo tepelně zpracováno v pokrmu

Nápoje Vhodné • Balená voda, minerální balené vody • Voda převařená (déle než 1 minutu) - převařenou vodu uchováváme v čisté, zakryté nádobě a uchováváme ji nejdéle 2 dny • Pacienti by se měli v místě bydliště informovat na hygienické stanici o kvalitě pitné vody • Čaj a káva, pokud byla při jejich přípravě použita převařená voda • Nápoje v plechovkách, lahvích a prášky pro výrobu nápojů, džus pasterovaný • Nutriční doplňky tekuté nebo práškové • Nápoje pro sportovce Nevhodné • Voda ze studny, točené pivo, víno, nepasterované ovocné a zeleninové džusy (šťávy) • Voda z vodovodu • Káva z automatu (nepřevařená voda)

Zásady nízkomikrobiální diety - shrnutí Zakázané potraviny ? ? ? ?

Zásady nízkomikrobiální diety - shrnutí Zakázané potraviny • Tepelně neupravené potraviny (mléko, maso, vejce) • Ohřáté pokrmy • Zrající, plísňové sýry • Jogurty s živou kulturou • Fermentované salámy • Salámy, sýry, pomazánky kupované za pultem • Ořechy a sušené ovoce častým zdrojem plísní! • Majonézy, dresinky (domácí) • Kysané zelí a jiná kvašená zelenina • Ovoce a zelenina, která jde špatně umýt • Uzené potraviny

Děkuji za pozornost

Literatura • KRČKOVÁ, K. Nízkomikrobiální strava onkologických pacientů. Brno: Masarykova univerzita, 2012. Bakalářská práce. • www. mnohocetnymyelom. cz/? p=124
- Slides: 31